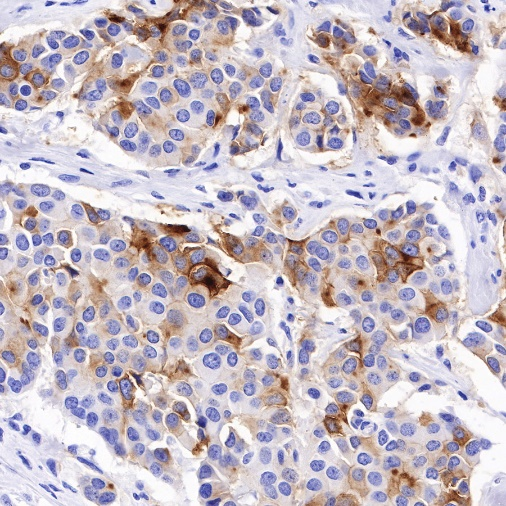
技术资料图片6

2 年
手机商铺
技术资料/正文
142 人阅读发布时间:2025-06-10 09:44
B7-H3
B7-H3(又称CD276)是一种I型跨膜蛋白,是B7家族中新发现的免疫调节蛋白成员,是癌症免疫治疗的关键靶标,因为它在肿瘤组织中过度表达,而在正常组织中表达有限,参与肿瘤微环境(TME)的塑造和发展。迄今为止,许多基于 B7-H3 的免疫治疗策略已在临床前模型中证明了有效的抗肿瘤活性和可接受的安全性。
许多研究表明B7-H3在许多肿瘤类型中过表达。它不会在淋巴细胞或淋巴细胞中低水平表达或表达,但在诱导时表现出增加的表达。这些表达模式意味着B7-H3可能在肿瘤发展和癌症免疫中发挥重要作用。

图1.B7-H3在TME中的作用
通过ADCC瞄准B7-H3
通过抗体-药物偶联物疗法靶向B7-H3抗体-药物偶联物(ADC)将mAb的靶标特异性与细胞毒性药物相结合,将细胞毒性药物递送到肿瘤并改善治疗指标。
目前,有超过90项临床试验已经或正在测试B7-H3靶向抗体、双抗、ADC以及CAR-T等免疫治疗策略的安全性和有效性。

图2.基于B7-H3的肿瘤免疫治疗策略。
B7-H4
B7-H4 是一种跨膜蛋白,是B7家族的重要成员。可结合活化 T 细胞上的未知受体,通过细胞周期停滞、减少增殖和减少 IL-2 产生来抑制 T 细胞效应功能。B7-H4在多种人类癌症的癌细胞和免疫抑制性肿瘤相关巨噬细胞(TAM)表面上调。值得注意的是,B7-H4表达水平与卵巢癌、胆管癌、乳腺癌和子宫内膜癌的患者生存率呈负相关,使B7-H4成为治疗肿瘤、炎症、自身免疫性疾病和器官移植的新型标志物或治疗靶点。

图3.阻断B7-H4:B7-H4R相互作用
StarMab®相关产品
B7H3作为免疫检查点的一个新兴靶点,对于B7家族的另一成员B7H4也开始走进人们的视野。肿瘤免疫治疗的未来趋势将涉及在新的靶点B7-H3、B7-H4的基础上研究不同类器官的细胞治疗。
斯达特生物紧随前沿靶点资讯,开发了一系列B7-H3/H4抗体、蛋白产品,助力抗体药物研发进程。
StarMab® B7-H3


抗体名称:S-RMab®B7-H3/CD276 Recombinant Rabbit mAb (SDT-R158)
组织类型:人结直肠癌、人乳腺癌
IHC染色定位:细胞膜
推荐货号:S0B2169
抗体类型:重组兔单抗
StarMab® B7-H4

抗体名称:B7-H4 Recombinant Rabbit mAb (SDT-314-447)
组织类型:人乳腺癌、人卵巢癌
IHC染色定位:细胞膜
推荐货号:S0B2234
抗体类型:重组兔单抗
点击下方的产品货号,直达官网详情页供您了解。

杭州斯达特 (www.starter-bio.com)志在为全球生命科学行业提供优质的抗体、蛋白、试剂盒等产品及研发服务。依托多个开发平台:重组兔单抗、重组鼠单抗、快速鼠单抗、重组蛋白开发平台(E.coli,CHO,HEK293,InsectCells),已正式通过欧盟98/79/EC认证、ISO9001认证、ISO13485。